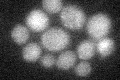
YGR185C
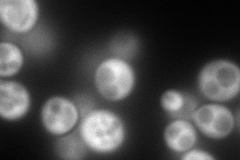
YGR185C
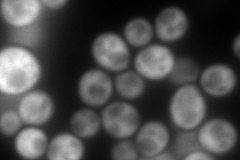
YGR185C
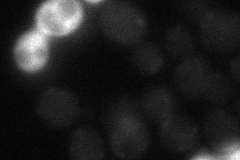
YGR185C
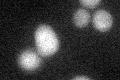
YGR185C
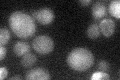
YGR185C

View description
Cytoplasmic tyrosyl-tRNA synthetase, required for cytoplasmic protein synthesis; interacts with positions 34 and 35 of the tRNATyr anticodon; mutations in human ortholog YARS are associated with Charcot-Marie-Tooth (CMT) neuropathies
Localization:
Intensity:
Fold change:
Significance:
-
C’ GFP library in SD
below threshold16.49 -
N' NOP1pr-GFP in SD
cytosol246.614 -
N' TEF2pr-mCherry in SD
cytosol352.073 -
N' NATIVEpr-GFP in SD
below threshold20.0591 -
N' TEF2pr-VC and Cyto-VN in SD

#N/A0 -
C’ GFP library in SD+DTT
cytosol14.830.89No -
C’ GFP library in SD+H2O2

cytosol17.241.04No -
C’ GFP library in Starvation Media
cytosol27.231.65No -
C’ GFP library on the background of Pup2-DaMP

below threshold -
C’ GFP library on the background of CCT mutant

below threshold16.84361.02079No
